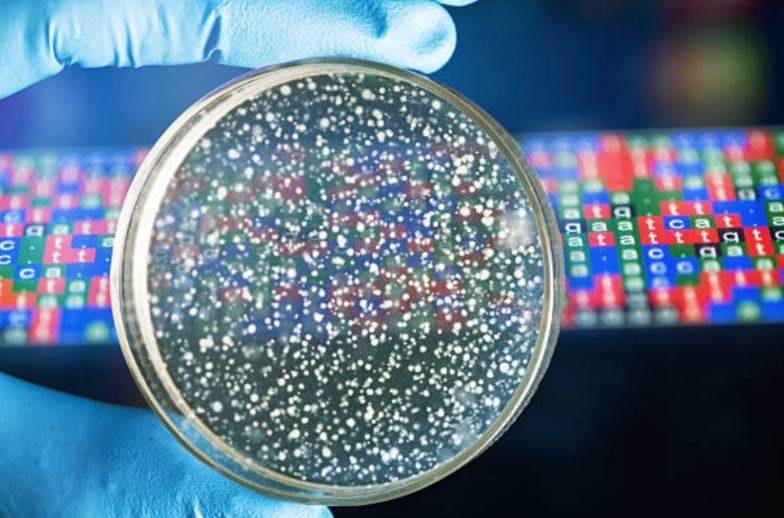

虽然在医护人员和普通民众的共同努力下,我们已经逐渐看到了攻克疫情的希望,但为了人类长久的健康,关于病毒的研究永远不能停止。

新型冠状病毒是如何跨越物种隔阂,从最初宿主打破层层屏障而传染给人类的?此类病毒应该如何抑制、如何预防?相信不久之后,研究人员们就会得出一系列结论,为人类社会稳定健康的发展做出贡献。他们将成为我们这个时代当之无愧的英雄!
那么能够从事这类研究的人员需要学习什么专业,感兴趣的小伙伴们从现在起应该往哪方面发展呢?答案就是—— 生物信息学(Bioinformatics) 。
没错,今天就为大家带来生物信息学的专业介绍,一起来看看吧!

生物信息学专业介绍
生物信息学(Bioinfomatics)是利用应用数学、信息学、统计学和计算机科学的方法研究生物学的问题。
生物信息学的研究材料和结果就是各种各样的生物学数据,其研究工具是计算机,研究方法包括对生物学数据的搜索(收集和筛选)、处理(编辑、整理、管理和显示)及利用(计算、模拟)。

在当前的疫情形势下,医护人员正是利用现有生物信息学最先进的研究体系,从大量数据中提取有用的生物信息并分析,解码基因组序列,为设计出新的救生药物而服务。无论是研发新冠病毒特效药还是面对未来未知的疾病,生物信息学都是至关重要的。
生物信息学结合了计算机应用和生物学知识,因此,毕业生未来就业方向比较广,以研究员、程序员、生物信息分析师为主。
大型职业网站Glassoor还对生物信息学专业的毕业生薪资做了统计,平均年薪达到了7万1加元。
生物信息学毕业生职业发展方向包括:
- 电脑科学家
- 生物信息学家
- 数据库开发人员
- 基因组分析技术员
- 计算机生物学家

湖首大学生物信息学专业
生物信息学是信息技术在分子生物学领域的应用。 作为一个相对较新的研究领域,湖首大学是加拿大为数不多的开设该专业的大学之一。
湖首大学开设的学位课程为:
- 理科荣誉学士学位(生物信息学)
湖首大学的生物信息学专业整合了来自多个学科的工具和理论,包括:数学、计算机科学、生物学、化学、物理。

作为生物信息学专业的学生,同学们将学习这个新兴领域前沿的知识,并有机会对医疗保健和社会可持续发展等问题进入深入研究。
湖首大学的课程内容包含:
- 生命系统的复杂相互作用
- 大数据收集与分析
- 环境的物理和化学性质
- 根据生物学数据建立描述性模型
- 理论生物学
湖首大学课程优势
本科生参与研究
作为一所研究型大学, 湖首大学本科学生参与研究的比例高达26% 。
湖首大学的教职员工积极参与各种相关领域的研究,让即使是本科在读的同学也有机会参与到重要的研究项目中去,为他们未来学术或工作道路打下坚实的基础。

小班教学
湖首大学的小班教学制度实行已久,深受学生们的好评。在人数不多的班级里,同学们不仅能够与其他同学互相督促、一起学习,还能随时与自己的老师交流、讨论,获得及时的帮助和指导。

就业支持
除此之外,湖首大学为学生们提供全面的就业支持,从简历修改、面试辅导,到一年多次的求职招聘会和行业联络活动,帮助同学们在自己的领域找到心仪的工作。
